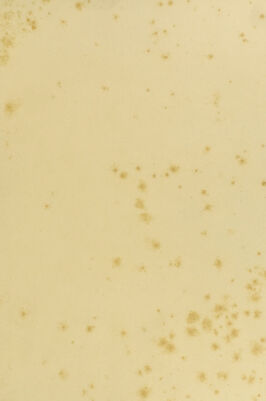

Hydrachnae, qvas in aqvis Daniae palvstribvs detexit, descripsit. Pingi et tabvlis XI aeneis incidi / cvravit Otho Fridericvs Mv̈ller.
- Otto Friedrich Müller
- Date:
- 1781
Licence: Public Domain Mark
Credit: Hydrachnae, qvas in aqvis Daniae palvstribvs detexit, descripsit. Pingi et tabvlis XI aeneis incidi / cvravit Otho Fridericvs Mv̈ller. Source: Wellcome Collection.
118/118